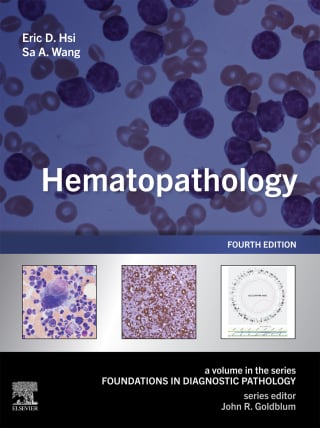

by Eric D. Hsi MD, Sa A. Wang MD, John R. Goldblum MD FCAP FASCP FACG
Part of the popular Foundations in Diagnostic Pathology Series, Hematopathology, Fourth Edition, is a practical and affordable resource that is ideal for study and review as well as everyday clinical practice. With its highly templated format, clearly written text, and concise summary tables, this user-friendly reference helps both trainees and practicing pathologists form accurate diagnoses, avoid pitfalls, and confidently sign out pathology reports on these often difficult and challenging cases.
Uses a highly templated format that includes clinical, imaging, and management/prognostic features; pathologic features; ancillary studies; differential diagnosis; and selected bibliography
Focuses on the specific features of various entities, including differential diagnoses
Supplements traditional morphologic diagnostic pathology with clinical, immunohistochemical, and molecular genetic information throughout
Includes new information on the molecular biology of benign and malignant hematologic disorders
Contains numerous quick-reference summary boxes that provide concise and handy key points on the clinical features and pathological features of each disease within hematopathology
Features hundreds of full-color photomicrographs and gross photographs that depict important pathologic features, enabling you to form a differential diagnosis and compare your findings with actual cases
Reflects updated disease classifications according to the 5th edition of World Health Organization (WHO) and The International Consensus Classification (ICC)
Offers contributions from internationally recognized pathologists, keeping you up to date with the latest information in the field
An eBook version is included with purchase. The eBook allows you to access all of the text, figures and references, with the ability to search, customize your content, make notes and highlights, and have content read aloud. Additional digital ancillary content may publish up to 6 weeks following the publication date

Reviews
There are no reviews yet.